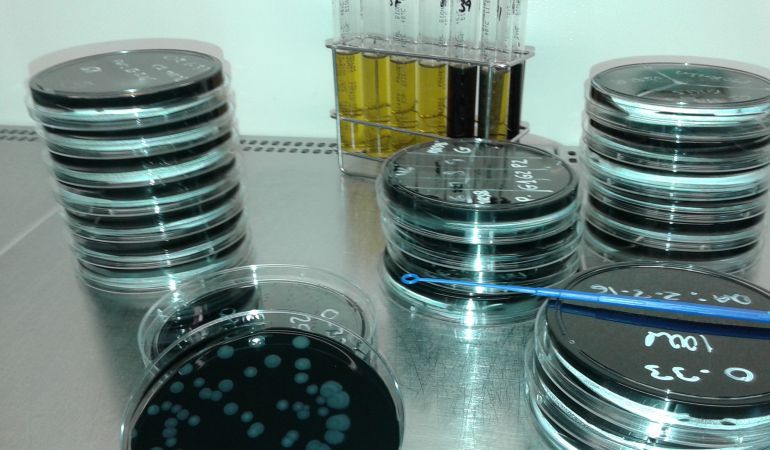
Noticias Mediodía Vigo 01/31/2018 Noticias Mediodía Vigo 01/31/2018

Noticias Vigo, 13.40
06/03/2025 12:22
Los votos del PSOE muestran el apoyo al trazado del futuro túnel entre Vigo y O Porriño
PP y BNG insistieron en que el PSOE en 2018 también exigía la gratuidad del tramo de la AP- 9 entre Vigo y Tui como alternativa a la actual A-55.
Avanzan los trámites del proyecto para unir Vigo y O Porriño a través de un túnel